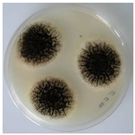
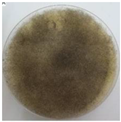

Microbial and Commercial Enzymes Applied in the Beverage Production Process
Abstract
1. Introduction
2. Enzymes Produced by Fungi (Moulds and Yeasts) in the Beverage Industry
3. Enzymes Produced by Lactic Acid Bacteria in the Beverage Industry
4. Enzymes from Grapes and Commercial Preparations Used in Wines Production
4.1. Enzymes from Grape Berry
4.2. Commercial Enzymatic Preparations Used in Wines Production
4.2.1. Pectinases
4.2.2. Cellulases and Hemicellulases
4.2.3. Glycosidases and Glucosidases
4.2.4. Glucanases
4.2.5. Urease
4.2.6. Lysozyme
4.3. Technological Application of Enzymes at Different Stages of the Winemaking Process
5. Future Trends in Enzyme Production and Usage
6. Final Remarks
Author Contributions
Funding
Institutional Review Board Statement
Informed Consent Statement
Data Availability Statement
Acknowledgments
Conflicts of Interest
References
- Robinson, P.K. Enzymes: Principles and biotechnological applications. Essays Biochem. 2015, 59, 1–41. [Google Scholar] [CrossRef] [PubMed]
- Mojsov, K.; Andronikov, D.; Janevski, A.; Jordeva, S.; Zezova, S. Enzymes and wine—the enhanced quality and yield. Adv. Technol. 2015, 4, 94–100. [Google Scholar] [CrossRef]
- Pretorius, I.S. Tailoring wine yeast for the new millennium: Novel approaches to the ancient art of winemaking. Yeast 2000, 16, 675–729. [Google Scholar] [CrossRef] [PubMed]
- Claus, H.; Mojsov, K. Enzymes for Wine Fermentation: Current and Perspective Applications. Fermentation 2018, 4, 52. [Google Scholar] [CrossRef]
- Aredes Fernández, P.A.; Stivala, M.G.; Rodríguez Vaquero, M.J.; Farías, M.E. Increase in antioxidant and antihypertensive activity by Oenococcus oeni in a yeast autolysis wine model. Biotechnol. Lett. 2011, 33, 359–364. [Google Scholar] [CrossRef] [PubMed]
- Hossain, M.B.; Ahmed, L. Chapter 6—Application of Enzymes in Juice Clarification. In Value-Addition in Beverages through Enzyme Technology; Kuddus, M., Hossain, M., Eds.; Academic Press: Cambridge, MA, USA, 2023; pp. 97–104. [Google Scholar] [CrossRef]
- Chandrasekaran, M.; Basheer, S.M.; Chellappan, S.; Krishna, J.G.; Beena, P.S. Enzymes in food and beverage produc-tion: An overview. In Section II: Applications of Enzymes in Food and Beverage Industries; CRC Press: Boca Raton, FL, USA, 2016; pp. 117–139. [Google Scholar]
- Uzuner, S.; Cekmecelioglu, D. Chapter 3—Enzymes in the Beverage Industry. In Enzymes in Food Biotechnology; Kuddus, M., Ed.; Academic Press: Cambridge, MA, USA, 2019; pp. 29–43. ISBN 9780128132807. [Google Scholar] [CrossRef]
- Mazrou, S.; Messaoudi, M.; Begaa, S.; Innocent, C.; Akretche, D. Clarification of the algerian grape juice and their effects on the juice quality. Bull. Chem. Soc. Ethiop. 2020, 34, 1–11. [Google Scholar] [CrossRef]
- Adrio, J.L.; Demain, A.L. Microbial enzymes: Tools for biotechnological processes. Biomol. Ther. 2014, 4, 117–139. [Google Scholar] [CrossRef]
- Markets and Markets. Global Food Enzymes Market Report. Global Food Enzymes Market 2023–2027. 2023, 181p. Available online: https://www.researchandmarkets.com/reports/4894548/global-food-enzymes-market-2023-2027#tag-pos-2 (accessed on 15 February 2023).
- Patel, A.K.; Singhania, R.R.; Pandey, A. Novel enzymatic processes applied to the food industry. Curr. Opin. Food Sci. 2016, 7, 64–72. [Google Scholar] [CrossRef]
- Arnau, J.; Yaver, D.; Hjort, C.M. Strategies and Challenges for the Development of Industrial Enzymes Using Fungal Cell Factories. In Grand Challenges in Fungal Biotechnology; Nevalainen, H., Ed.; Springer International Publishing: Cham, Switzerland, 2020; pp. 179–210. [Google Scholar] [CrossRef]
- Cairns, T.C.; Nai, C.; Meyer, V. How a fungus shapes biotechnology: 100 years of Aspergillus niger research. Fungal. Biol. Biotechnol. 2018, 5, 13. [Google Scholar] [CrossRef]
- Coutinho, P.M.; Reilly, P.J. Glucoamylase structural, functional and evolutionary relationships. Proteins 1997, 29, 334–347. [Google Scholar] [CrossRef]
- Raveendran, S.; Parameswaran, B.; Ummalyma, S.B.; Abraham, A.; Mathew, A.K.; Madhavan, A.; Rebello, S.; Pandey, A. Applications of Microbial Enzymes in Food Industry. Food Technol. Biotechnol. 2018, 56, 16–30. [Google Scholar] [CrossRef] [PubMed]
- Deng, L.; Wang, Z.; Yang, S.; Song, J.; Que, F.; Zhang, H.; Feng, F. Improvement of functional properties of wheat gluten using acid protease from Aspergillus usamii. PLoS ONE 2016, 11, e0160101. [Google Scholar] [CrossRef] [PubMed]
- Copetti, M.A. Fungi as industrial producers of food ingredients. Curr. Opin. Food Sci. 2019, 25, 52–56. [Google Scholar] [CrossRef]
- De Carvalho, C.; da Fonseca, M.M.R. Bacterial whole cell biotransformations: In vivo reactions under in vitro conditions. Dyn. Biochem. Process. Biotechnol. Mol. Biol. 2007, 1, 32–39. [Google Scholar]
- Virdis, C.; Sumby, K.; Bartowsky, E.; Jiranek, V. Lactic acid bacteria in wine: Technological advances and evaluation of their functional role. Front. Microbiol. 2021, 11, 612118. [Google Scholar] [CrossRef]
- Inês, A.; Falco, V. Lactic acid bacteria contribution to wine quality and safety. In Generation of Aromas and Flavours; Vilela, A., Ed.; IntechOpen: London, UK, 2018. [Google Scholar] [CrossRef]
- Paramithiotis, S.; Stasinou, V.; Tzamourani, A.; Kotseridis, Y.; Dimopoulou, M. Malolactic Fermentation—Theoretical Advances and Practical Considerations. Fermentation 2022, 8, 521. [Google Scholar] [CrossRef]
- Liu, S. A review: Malolactic fermentation in wine—Beyond deacidification. J. Appl. Microbiol. 2002, 92, 589–601. [Google Scholar] [CrossRef]
- Arnink, K.; Henick-Kling, T. Influence of Saccharomyces cerevisiae and Oenococcus oeni strains on successful malolactic conversion in wine. Am. J. Enol. Vitic. 2005, 56, 228–237. [Google Scholar] [CrossRef]
- Bartowsky, E.; Burvill, T.; Henschke, P. Diacetyl in Wine: Role of Malolactic Bacteria and Citrate. Aust. N. Z. Grapegrow. Winemak. 1997, 130–135. [Google Scholar]
- Bartowsky, E.; Henschke, P. Management of Malolactic Fermentation for the ‘Buttery’ Diacetyl Flavour in Wine. Aust. N. Z. Grapegrow. Winemak. 2000, 58–67. [Google Scholar]
- Bartowsky, E.; Henschke, P. The ‘buttery’ attribute of wine–diacetyl-desirability, spoilage and beyond. Int. J. Food Microbiol. 2004, 96, 235–252. [Google Scholar] [CrossRef] [PubMed]
- Sumby, K.M.; Jiranek, V.; Grbin, P.R. Ester synthesis and hydrolysis in an aqueous environment, and strain specific changes during malolactic fermentation in wine with Oenococcus oeni. Food Chem. 2013, 141, 1673–1680. [Google Scholar] [CrossRef] [PubMed]
- Günata, Z.; Bitteur, S.; Brillouet, J.-M.; Bayonove, C.; Cordonnier, R. Sequential enzymic hydrolysis of potentially aromatic glycosides from grape. Carbohydrate Res. 1988, 184, 139–149. [Google Scholar] [CrossRef]
- Grimaldi, A.; Bartowsky, E.; Jiranek, V. Screening of Lactobacillus spp. and Pediococcus spp. for glycosidase activities that are important in oenology. J. Appl. Microbiol. 2005, 99, 1061–1069. [Google Scholar] [CrossRef]
- Grimaldi, A.; McLean, H.; Jiranek, V. Identification and partial characterization of glycosidic activities of commercial strains of the lactic acid bacterium, Oenococcus oeni. Am. J. Enol. Vitic. 2000, 51, 362–369. [Google Scholar] [CrossRef]
- Grimaldi, A.; Bartowsky, E.; Jiranek, V. A survey of glycosidase activities of commercial wine strains of Oenococcus oeni. Int. J. Food Microbiol. 2005, 105, 233–244. [Google Scholar] [CrossRef]
- Spano, G.; Rinaldi, A.; Ugliano, M.; Moio, L.; Beneduce, L.; Massa, S. A β-glucosidase gene isolated from wine Lactobacillus plantarum is regulated by abiotic stresses. J. Appl. Microbiol. 2005, 98, 855–861. [Google Scholar] [CrossRef]
- Hernandez-Orte, P.; Cersosimo, M.; Loscos, N.; Cacho, J.; Garcia-Moruno, E.; Ferreira, V. Aroma development from non-floral grape precursors by wine lactic acid bacteria. Food Res. Int. 2009, 42, 773–781. [Google Scholar] [CrossRef]
- Zheng, J.; Wittouck, S.; Salvetti, E.; Franz, C.M.A.P.; Harris, H.M.B.; Mattarelli, P.; O’Toole, P.W.; Pot, B.; Vandamme, P.; Walter, J.; et al. A taxonomic note on the genus Lactobacillus: Description of 23 novel genera, emended description of the genus Lactobacillus Beijerinck 1901, and union of Lactobacillaceae and Leuconostocaceae. Int. J. Syst. Evol. Microbiol. 2020, 4, 2782–2858. [Google Scholar] [CrossRef] [PubMed]
- Lerm, E.; Engelbrecht, L.; du Toit, M. Selection and Characterisation of Oenococcus oeni and Lactobacillus plantarum South African Wine Isolates for Use as Malolactic Fermentation Starter Cultures. S. Afr. J. Enol. Vitic. 2011, 32, 280–295. [Google Scholar] [CrossRef]
- Iorizzo, M.; Testa, B.; Lombardi, S.J.; García-Ruiz, A.; Muñoz-González, C.; Bartolomé, B.; Moreno-Arribas, M.V. Selection and technological potential of Lactobacillus plantarum bacteria suitable for wine malolactic fermentation and grape aroma release. LWT- Food Sci. Technol. 2016, 73, 557–566. [Google Scholar] [CrossRef]
- Krieger-Weber, S.; Heras, J.M.; Suarez, C. Lactobacillus plantarum, a New Biological Tool to Control Malolactic Fermentation: A Review and an Outlook. Beverages 2020, 6, 23. [Google Scholar] [CrossRef]
- Kennison, K.R.; Wilkinson, K.L.; Williams, H.G.; Smith, J.H.; Gibberd, M.R. Smoke-derived taint in wine: Effect of postharvest smoke exposure of grapes on the chemical composition and sensory characteristics of wine. J. Agric. Food Chem. 2007, 55, 10897–10901. [Google Scholar] [CrossRef] [PubMed]
- Jiranek, V. Smoke taint compounds in wine: Nature, origin, measurement and amelioration of affected wines: Smoke taint compounds in wine. Aust. J. Grape Wine Res. 2011, 17, S2–S4. [Google Scholar] [CrossRef]
- Waterhouse, A.L.; Sacks, G.L.; Jeffery, D.W. Understanding Wine Chemistry; John Wiley & Sons, Incorporated: New York, NY, USA, 2016. [Google Scholar]
- Sumby, K.M.; Grbin, P.R.; Jiranek, V. Microbial modulation of aromatic esters in wine: Current knowledge and future prospects. Food Chem. 2010, 121, 1–16. [Google Scholar] [CrossRef]
- Ugliano, M.; Moio, L. Changes in the concentration of yeast-derived volatile compounds of red wine during malolactic fermentation with four commercial starter cultures of Oenococcus oeni. J. Agric. Food Chem. 2005, 53, 10134–10139. [Google Scholar] [CrossRef]
- Antalick, G.; Perello, M.-C.; de Revel, G. Characterization of fruity aroma modifications in red wines during malolactic fermentation. J. Agric. Food Chem. 2012, 60, 12371–12383. [Google Scholar] [CrossRef]
- Costello, P.; Déléris-Bou, M.; Descenzo, R.; Hall, N.; Krieger, S.; Lonvaud Funel, A. Strain selection techniques. In Malolactic Fermentation—Importance of Wine Lactic Acid Bacteria in Winemaking; Morenzoni, R., Specht, K.S., Eds.; Lallemand Inc.: Montréal, QC, Canada, 2015. [Google Scholar]
- Lytra, G.; Miot-Sertier, C.; Moine, V.; Coulon, J.; Barbe, J.-C. Influence of must yeast-assimilable nitrogen content on fruity aroma variation during malolactic fermentation in red wine. Food Res. Int. 2020, 135, 109294. [Google Scholar] [CrossRef]
- Pérez-Martín, F.; Seseña, S.; Izquierdo, P.M.; Palop, M.L. Esterase activity of lactic acid bacteria isolated from malolactic fermentation of red wines. Int. J. Food Microbiol. 2013, 163, 153–158. [Google Scholar] [CrossRef]
- Gammacurta, M.; Lytra, G.; Marchal, A.; Marchand, S.; Christophe Barbe, J.; Moine, V. Influence of lactic acid bacteria strains on ester concentrations in red wines: Specific impact on branched hydroxylated compounds. Food Chem. 2018, 239, 252–259. [Google Scholar] [CrossRef]
- Lasik-Kurdyś, M.; Majcher, M.; Nowak, J. Effects of Different Techniques of Malolactic Fermentation Induction on Diacetyl Metabolism and Biosynthesis of Selected Aromatic Esters in Cool-Climate Grape Wines. Molecules 2018, 23, 2549. [Google Scholar] [CrossRef] [PubMed]
- Claus, H. Microbial Enzymes: Relevance for Winemaking. In Biology of Microorganisms on Grapes, in Must and in Wine, 2nd ed.; König, H., Unden, G., Fröhlich, J., Eds.; Springer International Publishing: Cham, Switzerland, 2017; pp. 315–338. [Google Scholar]
- Matthews, A.; Grbin, P.R.; Jiranek, V. A survey of lactic acid bacteria for enzymes of interest in oenology. Aust. J. Grape Wine Res. 2006, 12, 235–244. [Google Scholar] [CrossRef]
- Nkemnaso, Obi Clifford, Enzymatic Potentials of Lactic Acid Bacteria Isolated from Palm Wine international. J. Bioinform. Biomed. Eng. 2018, 4, 56–61. Available online: http://www.aiscience.org/journal/ijbbe (accessed on 20 January 2023).
- Manca de Nadra, M.C.; Farías, M.E.; Moreno-Arribas, V.; Pueyo, E.; Polo, M.C. A proteolytic effect of Oenococcus oeni on the nitrogenous macromolecular fraction of red wine. FEMS Microbiol. Lett. 1999, 174, 41–47. [Google Scholar] [CrossRef]
- Farías, M.E.; Manca de Nadra, M.C. Purification and partial characterization of Oenococcus oeni exoprotease. FEMS Microbiol. Lett. 2000, 185, 263–266. [Google Scholar] [CrossRef]
- Manca de Nadra, M.C.; Farias, M.E.; Pueyo, E.; Polo, M.C. Protease activity of Oenococcus oeni viable cells on red wine nitrogenous macromolecular fraction in presence of SO2 and ethanol. Food Control 2004, 16, 851–854. [Google Scholar] [CrossRef]
- Folio, P.; Ritt, J.F.; Alexandre, H.; Remize, F. Characterization of EprA, a major extracellular protein of Oenococcus oeni with protease activity. Int. J. Food Microbiol. 2008, 127, 26–31. [Google Scholar] [CrossRef]
- Dicks, L.M.T.; Van Vuuren, H.J.J. Identification and physiological characteristics of heterofermentative strains of Lactobacillus from South African red wines. J. Appl. Bacteriol. 1988, 64, 505–514. [Google Scholar] [CrossRef]
- Vaquero, I.; Marcobal, A.; Munoz, R. Tannase activity by lactic acid bacteria isolated from grape must and wine. Int. J. Food Microbiol. 2004, 96, 199–204. [Google Scholar] [CrossRef]
- Mesas, J.M.; Rodríguez, M.C.; Alegre, M.T. Characterization of lactic acid bacteria from musts and wines of three consecutive vintages of Ribeira Sacra. Lett. Appl. Microbiol. 2011, 52, 258–268. [Google Scholar] [CrossRef] [PubMed]
- Bravo-Ferrada, B.M.; Hollmann, A.; Delfederico, L.; Valdés La Hens, D.; Caballero, A.; Semorile, L. Patagonian red wines: Selection of Lactobacillus plantarum isolates as potential starter cultures for malolactic fermentation. World J. Microbiol. Biotechnol. 2013, 9, 1537–1549. [Google Scholar] [CrossRef] [PubMed]
- Bravo-Ferrada, B.M.; Hollmann, A.; Brizuela, N.; La Hens, D.V.; Tymczyszyn, E.; Semorile, L. Growth and consumption of L-malic acid in wine-like medium by acclimated and non-acclimated cultures of Patagonian Oenococcus oeni strains. Folia Microbiol. 2016, 61, 365–373. [Google Scholar] [CrossRef] [PubMed]
- Callejón, S.; Sendra, R.; Ferrer, S.; Pardo, I. Cloning and characterization of a new laccase from Lactobacillus plantarum J16 CECT 8944 catalyzing biogenic amine degradation. Appl. Microbiol. Biotechnol. 2016, 100, 3113–3124. [Google Scholar] [CrossRef]
- Callejón, S.; Sendra, R.; Ferrer, S.; Pardo, I. Identification of a novel enzymatic activity from lactic acid bacteria able to degrade biogenic amines in wine. Appl. Microbiol. Biotechnol. 2014, 98, 185–198. [Google Scholar] [CrossRef]
- Olmeda, I.; Casino, P.; Collins, R.E.; Sendra, R.; Callejón, S.; Huesa, J.; Soares, A.S.; Ferrer, S.; Pardo, I. Structural analysis and biochemical properties of laccase enzymes from two Pediococcus species. Microb. Biotechnol. 2021, 3, 1026–1043. [Google Scholar] [CrossRef]
- Niu, T.; Li, X.; Guo, Y.; Ma, Y. Identification of a Lactic Acid Bacteria to Degrade Biogenic Amines in Chinese Rice Wine and Its Enzymatic Mechanism. Foods 2019, 8, 312. [Google Scholar] [CrossRef] [PubMed]
- Muhialdin, B.J.; Saari, N.; Meor Hussin, A.S. Review on the Biological Detoxification of Mycotoxins Using Lactic Acid Bacteria to Enhance the Sustainability of Foods Supply. Molecules 2020, 25, 2655. [Google Scholar] [CrossRef]
- Abrunhosa, L.; Inês, A.; Rodrigues, A.I.; Guimarães, A.; Pereira, V.L.; Parpot, P.; Mendes-Faia, A.; Venâncio, A. Biodegradation of ochratoxin A by Pediococcus parvulus isolated from Douro wines. Int. J. Food Microbiol. 2014, 188, 45–52. [Google Scholar] [CrossRef]
- Ottone, C.; Romero, O.; Aburto, C.; Illanes, A.; Wilson, L. Biocatalysis in the winemaking industry: Challenges and opportunities for immobilized enzymes. Compr. Rev. Food Sci. Food Saf. 2019, 19, 595–621 . [Google Scholar] [CrossRef]
- Ducasse, M.A.; Williams, P.; Canal-Llauveres, R.M.; Mazerollest, G.; Cheynier, V.; Doco, T. Effect of macerating enzymes on the oligosaccharide profiles of Merlot red wines. J. Agric. Food Chem. 2011, 59, 6558–6567. [Google Scholar] [CrossRef]
- Ray, R.C.; Rosell, C.M. (Eds.) Microbial Enzyme Technology in Food Applications, 1st ed.; CRC Press: Boca Raton, FL, USA, 2017. [Google Scholar] [CrossRef]
- Sahay, S. Wine Enzymes: Potential and Practices. In Enzymes in Food Biotechnology; Kuddus, M., Ed.; Academic Press: Cambridge, MA, USA, 2019; Chapter 6; pp. 73–92. [Google Scholar] [CrossRef]
- Gaspar, L.M.; Machado, A.; Coutinho, R.; Sousa, S.; Santos, R.; Xavier, A.; Figueiredo, M.; Teixeira, M.F.; Centeno, F.; Simões, J. Development of Potential Yeast Protein Extracts for Red Wine Clarification and Stabilization. Front. Microbiol. 2019, 10, 2310. [Google Scholar] [CrossRef] [PubMed]
- Fia, G. Wine Lees: Traditional and Potential Innovative Techniques for their Exploitation in Winemaking. In Grape and Wine Biotechnology; IntechOpen: London, UK, 2016; pp. 345–359. [Google Scholar] [CrossRef]
- De Iseppi, A.; Lomolino, G.; Marangon, M.; Curioni, A. Current and future strategies for wine yeast lees valorization. Food Res. Int. 2020, 137, 109352. [Google Scholar] [CrossRef] [PubMed]
- Maicas, S.; Mateo, J.J. Microbial Glycosidases for Wine Production. Beverages 2016, 2, 20. [Google Scholar] [CrossRef]
- Karnišová-Potocká, E.; Mastihubová, M.; Mastihuba, V. Apiose-Relevant Glycosidases. Catalysts 2021, 11, 1251. [Google Scholar] [CrossRef]
- Hüfner, E.; Haßelbeck, G. Application of microbial enzymes during winemaking. In Biology of Microorganisms on Grapes, in Must and in Wine, 2nd ed.; König, H., Unden, G., Fröhlich, J., Eds.; Springer International Publishing: Cham, Switzerland, 2017; pp. 635–658. [Google Scholar]
- Van Rensburg, P.; Pretorius, I.S. Enzymes in winemaking. Harnessing Natural Catalysts for Efficient Biotransformations—A Review. S. Afr. J. Enol. Vitic. 2000, 21, 52–73. [Google Scholar]
- OIV (Organisation International de la Vigne et du Vin). International Code Oenological Practices; Edition Officielle: Paris, France, 2022. [Google Scholar]
- OIV (Organisation International de la Vigne et du Vin). International Oenological Codex; Edition Officielle: Paris, France, 2022. [Google Scholar]
- Deytieux-Belleau, C.; Vallet, A.; Donéche, B.; Geny, L. Pectin methylesterase and polygalacturonase in the developing grape skin. Plant Physiol. Biochem. 2008, 46, 638e646. [Google Scholar] [CrossRef]
- Villettaz, J.C. Les enzymes en œnologie. Bull. de l’O.I.V. 1984, 635, 19–29. [Google Scholar]
- Pretorius, I.S. Utilisation of polysaccharides by Saccharomyces cerevisiae. In Yeast Sugar Metabolism—Biochemistry, Genetics, Biotechnology and Applications; Zimmermann, F.K., Entaian, K.D., Eds.; Technomic Publishing Co.: Lancaster, PA, USA, 1997; pp. 459–501. [Google Scholar]
- Aryan, A.R.; Wilson, B.; Strauss, C.R.; Williams, P.J. The Properties of Glycosidases of Vitis vinifera and a Comparison of Their Beta-Glycosidase Activity with That of Exogenous Enzymes. An Assessment of Possible Applications in Enology. Am. J. Enol. Vitic. 1987, 38, 182–188. [Google Scholar] [CrossRef]
- Günata, Y.Z.; Biron, C.; Sapis, J.C.; Bayonove, C. Glycosidase activities in sound and rotten grapes in relation to hydrolysis of grape monoterpenyl glycosides. Vitis 1989, 28, 191–197. [Google Scholar]
- Sarry, J.E.; Günata, Z. Plant and Microbial Glycoside Hydrolases: Volatile Release from Glycosidic Aroma Precursors. Food Chem. 2004, 87, 509–521. [Google Scholar] [CrossRef]
- Loscos, N.; Hernandez-Orte, P.; Cacho, J.; Ferreira, V. Release and formation of varietal aroma compounds during alcoholic fermentation from non-floral grape odorless flavor precursors fractions. J. Agric. Food Chem. 2007, 55, 6674–6684. [Google Scholar] [CrossRef] [PubMed]
- López-Miranda, S.; Hernández-Sánchez, P.; Serrano-Martínez, A.; Hellínb, J.; Fenoll, P.; Núñez-Delicado, E. Effect of ripening on protein content and enzymatic activity of Crimson Seedless table grape. Food Chem. 2011, 127, 481–486. [Google Scholar] [CrossRef] [PubMed]
- Orenes-Piñero, E.; García-Carmona, F.; Sánchez-Ferrer, A. Latent of polyphenol oxidase from quince fruit pulp (Cydonia oblonga): Purification, activation and some properties. J. Sci. Food Agric. 2006, 86, 2172–2178. [Google Scholar] [CrossRef]
- Gandía-Herrero, F.; García-Carmona, F.; Escribano, J. Purification and characterization of a latent polyphenol oxidase from beet root (Beta vulgaris L.). J. Agric. Food Chem. 2004, 52, 609–615. [Google Scholar] [CrossRef] [PubMed]
- Fronk, P.; Hartmann, H.; Bauer, M.; Solem, E.; Jaenicke, E.; Tenzer, S.; Decker, H. Polyphenoloxidase from Riesling and Dornfelder wine grapes (Vitis vinfera) is a tyrosinase. Food Chem. 2015, 183, 49–57. [Google Scholar] [CrossRef] [PubMed]
- Richard-Forget, F.C.; Gauillard, F.A. Oxidation of chlorogenic acid, catechins and 4-methylcatechol in model solutions by combinations of pear (Pyrus communis cv. Williams) polyphenol oxidase and peroxidase: A possible involvement of peroxidase in enzymatic browning. J. Agric. Food Chem. 1997, 45, 2472–2476. [Google Scholar] [CrossRef]
- Kavuthodi, B.; Sebastian, D. Review on bacterial production of alkaline pectinase with special emphasis on Bacillus species. Biosci. Biotechnol. Res. Commun. 2018, 11, 18–30. [Google Scholar] [CrossRef]
- Sudeep, K.C.; Upadhyaya, J.; Joshi, D.R.; Lekhak, B.; Chaudhary, D.K.; Pant, B.R.; Bajgai, T.R.; Dhital, R.; Khanal, S.; Koirala, N.; et al. Production, Characterization, and Industrial Application of Pectinase Enzyme Isolated from Fungal Strains. Fermentation 2020, 6, 59. [Google Scholar] [CrossRef]
- Cornuault, V.; Posé, S.; Knox, J.P. Disentangling pectic homogalacturonan and rhamnogalacturonan-I polysaccharides: Evidence for sub-populations in fruit parenchyma systems. Food Chem. 2018, 246, 275–285. [Google Scholar] [CrossRef]
- Kuhad, R.C.; Gupta, R.; Singh, A. Microbial cellulases and their industrial applications. Enzyme Res. 2011, 2011, 280696. [Google Scholar] [CrossRef]
- Gilkes, N.R.; Henrissat, B.; Kilburn, D.G.; Miller, R.C.; Warren, R.A.J. Domains in microbial b-1-4-glycanases: Sequence conservation, function, and enzymes families. Microbiol. Rev. 1991, 55, 303–315. [Google Scholar] [CrossRef] [PubMed]
- Doco, T.; Williams, P.; Pauly, M.; O’Neill, M.A.; Pellerin, P. Polysaccharides from grape berry cell walls. Part II. Structuralcharacterization of the xyloglucan polysaccharides. Carbohydr. Polym. 2003, 53, 253e261. [Google Scholar] [CrossRef]
- Hjelmeland, A.K.; Ebeler, S.E. Glycosidically Bound Volatile Aroma Compounds in Grapes and Wine: A Review. Am. J. Enol. Vitic. 2015, 66, 1–11. [Google Scholar] [CrossRef]
- Dubourdieu, D.; Ribéreau-Gayon, P. Structure of the exocellular beta-D-glucan from Botrytis cinerea. Carbohydr. Res. 1981, 93, 294–299. [Google Scholar] [CrossRef]
- Dubourdieu, D.; Desplanques, C.; Villettaz, J.-C.; Ribéreau-Gayon, P. Investigations of an industrial β-D-glucanase from Trichoderma harzianum. Carbohydr. Res. 1985, 144, 277–287. [Google Scholar] [CrossRef]
- Venturi, F.; Andrich, G.; Quartacci, M.F.; Sanmartin, C.; Andrich, L.; Zinnai, A. A kinetic method to identify the optimum temperature for glucanase activity. S. Afr. J. Enol. Vitic. 2013, 34, 281–286. [Google Scholar] [CrossRef]
- Villettaz, J.-C.; Steiner, D.; Trogus, H. The use of glucanase as an enzyme in wine clarification and filtration. Am. J. Enol. Vitic. 1984, 35, 253–256. [Google Scholar] [CrossRef]
- Nebreda, A.R.; Villa, T.G.; Villanueva, J.R.; del Rey, F. Cloning of genes related to exo-beta-glucanase production in Saccharomyces cerevisiae: Characterization of an exo-beta-glucanase structural gene. Gene 1986, 47, 245–259. [Google Scholar] [CrossRef]
- Gowd, V.; Su, H.; Karlovsky, P.; Chen, W. Ethyl carbamate: An emerging food and environmental toxicant. Food Chem. 2018, 248, 312–321. [Google Scholar] [CrossRef]
- Fujinawa, S.; Burns, G.; De La Teja, P. Application of acid urease to reduction of urea in commercial wines. Am. J. Enol. Vitic. 1990, 41, 350–354. [Google Scholar] [CrossRef]
- Fidaleo, M.; Esti, M.; Moresi, M. Assessment of urea degradation rate in model wine solutions by acid urease from Lactobacillus fermentum. J. Agric. Food. Chem. 2006, 54, 6226–6235. [Google Scholar] [CrossRef] [PubMed]
- Ough, C.S.; Trioli, G. Urea removal from wine by an acid urease. Am. J. Enol. Vitic. 1988, 39, 303. [Google Scholar] [CrossRef]
- Proctor, V.A.; Cunningham, F.E. The chemistry of lysozyme and its use as a food preservative and a pharmaceutical. CRC Crit. Rev. Food Sci. Nutr. 1988, 26, 359–395. [Google Scholar] [CrossRef] [PubMed]
- Gerbaux, V.; Villa, A.; Monamy, C.; Bertand, A. Use of lysozyme to inhibit malolactic fermentation and to stabilize wine after malolactic fermentation. Am. J. Enol. Vitic. 1997, 48, 49–54. [Google Scholar] [CrossRef]
- Liburdi, K.; Benucci, I.; Esti, M. Lysozyme in wine: An overview of current and future applications. Compr. Rev. Food Sci. Food Saf. 2014, 13, 1062–1073. [Google Scholar] [CrossRef]
- Pinelo, M.; Arnous, A.; Meyer, A.S. Upgrading of grape skins: Significance of plant cell wall structural components and extraction techniques for phenol release. Trends Food Sci. Technol. 2006, 17, 579–590. [Google Scholar] [CrossRef]
- Espejo, F. Role of commercial enzymes in wine production: A critical review of recent research. J. Food Sci. Technol. 2021, 58, 9–21. [Google Scholar] [CrossRef]
- Garg, G.; Singh, A.; Kaur, A.; Singh, R.; Kaur, J.; Mahajan, R. Microbial pectinases: An ecofriendly tool of nature for industries. 3 Biotech 2016, 6, 47. [Google Scholar] [CrossRef]
- Guerin, L.; Chatelet, B.; Anneraud, C.; Vinsonneau, E.; Davaud, F.; Solanet, D.; Vuchot, P. Les enzymes en œnologie- 2ème volet: Intérêt dans les opérations fermentaires sur vin rouge. Rev. Française D’œnologie 2011, 244, 7–18. [Google Scholar]
- Ducasse, M.-A.; Canal-Llauberes, R.-M.; de Lumley, M.; Williams, P.; Souquet, J.-M.; Fulcrand, H.; Doco, T.; Cheynier, V. Effect of macerating enzyme treatment on the polyphenol and polysaccharide composition of red wines. Food Chem. 2010, 118, 369–376. [Google Scholar] [CrossRef]
- Samoticha, J.; Wojdylo, A.; Chmielewska, J.; Politowicz, J.; Szumny, A. The effects of enzymatic pre-treatment and type of yeast on chemical properties of white wine. LWT Food Sci. Technol. 2017, 79, 445–453. [Google Scholar] [CrossRef]
- Fontes, N.; Gerós, H.; Delrot, S. Grape berry vacuole: A complex and heterogeneous membrane system specialized in the accumulation of solutes. Am. J. Enol. Vitic. 2011, 62, 270–278. [Google Scholar] [CrossRef]
- El Darra, N.E.; Turk, M.F.; Ducasse, M.A.; Grimi, N.; Maroun, R.G.; Louka, N.; Vorobiev, E. Changes in polyphenol profiles and colour composition of freshly fermented model wine due to pulsed electric field, enzymes and thermovinification pretreatments. Food Chem. 2016, 194, 944–950. [Google Scholar] [CrossRef] [PubMed]
- Romero-Cascales, I.; Ros-García, J.M.; López-Roca, J.M.; Gómez-Plaza, E. The effect of a commercial pectolytic enzyme on grape skin cell wall degradation and colour evolution during the maceration process. Food Chem. 2012, 130, 626–631. [Google Scholar] [CrossRef]
- Lecas, M.; Brillouet, J.-M. Cell wall composition of grape berry skins. Phytochemistry 1994, 35, 1241e1243. [Google Scholar] [CrossRef]
- Bautista-Ortín, A.B.; Martínez-Cutillas, A.; Ros-García, J.; López-Roca, J.M.; Gómez-Plaza, E. Improving colour extraction and stability in red wines: The use of maceration enzymes and enological tannins. Int. J. Food Sci. 2005, 40, 867–878. [Google Scholar] [CrossRef]
- Kelebek, H.; Canbas, A.; Cabaroglu, T.; Selli, S. Improvement of anthocyanin content in the cv. Öküzgözü wines by using pectolytic enzymes. Food Chem. 2007, 105, 334–339. [Google Scholar] [CrossRef]
- Li, S.Y.; Liu, P.T.; Pan, Q.H.; Shi, Y.; Duan, C.Q. Association between modification of phenolic profiling and development of wine color during alcohol fermentation. J. Food Sci. 2015, 80, C703–C710. [Google Scholar] [CrossRef] [PubMed]
- Sacchi, K.L.; Bisson, L.F.; Adams, D.O. A review of the effect of winemaking techniques on phenolic extraction in red wines. Am. J. Enol. Vitic. 2005, 56, 197–206. [Google Scholar] [CrossRef]
- Maicas, S.; Mateo, J.J. Hydrolysis of terpenyl glycosides in grape juice and other fruit juices: A review. Appl. Microbiol. Biotechnol. 2005, 67, 322–335. [Google Scholar] [CrossRef]
- Black, C.A.; Parker, M.; Siebert, T.E.; Capone, D.L.; Francis, I.L. Terpenoids and their role in wine flavour: Recent advances. Aust. J. Grape Wine Res. 2015, 21, 582–600. [Google Scholar] [CrossRef]
- Sánchez-Palomo, E.; Díaz-Maroto Hidalgo, M.C.; González-Viñas, M.A.; Pérez-Coello, M.S. Aroma enhancement in wines from different grape varieties using exogenous glycosidases. Food Chem. 2005, 92, 627–635. [Google Scholar] [CrossRef]
- Pogorzelski, E.; Wilkowska, A. Flavour enhancement through the enzymatic hydrolysis of glycosidic aroma precursors in juices and wine beverages: A review. Flavour. Fragr. J. 2007, 22, 251–254. [Google Scholar] [CrossRef]
- Bisotto, A.; Julien, A.; Rigou, P.; Schneider, R.; Salmon, J.M. Evaluation of the inherent capacity of commercial yeast strains to release glycosidic aroma precursors from Muscat grape must. Aust. J. Grape Wine Res. 2015, 21, 194–199. [Google Scholar] [CrossRef]
- Di Profio, F.; Reynolds, A.G.; Kasimos, A. Canopy management and Eenzyme impacts on Merlot, Cabernet Franc, and Cabernet Sauvignon. I. Yield and berry composition. Am. J. Enol. Vitic. 2011, 62, 139–151. [Google Scholar] [CrossRef]
- González-Barreiro, C.; Rial-Otero, R.; Cancho-Grande, B.; Simal-Gándara, J. Wine aroma compounds in grapes: A critical review. Crit. Rev. Food Sci. Nutr. 2015, 55, 202–218. [Google Scholar] [CrossRef]
- Waters, E.J.; Shirley, N.J.; Williams, P.J. Nuisance proteins of wine are grape pathogenesisrelated proteins. J. Agric. Food Chem. 1996, 44, 3–5. [Google Scholar] [CrossRef]
- Waters, E.J.; Hayasaka, Y.; Tatersall, D.B.; Adams, K.S.; Williams, P.J. Sequence analysis of grape (Vitis vinifera) berry chitinases that cause haze formation in wines. J. Agric. Food Chem. 1998, 45, 4950–4957. [Google Scholar] [CrossRef]
- Marangon, M.; Van Sluyter, S.C.; Neilson, K.A.; Chan, C.; Haynes, P.A.; Waters, E.J.; Falconer, R.J. Roles of grape thaumatin-like protein and chitinase in white wine haze formation. J. Agric. Food Chem. 2011, 59, 733–740. [Google Scholar] [CrossRef]
- Marangon, M.; Van Sluyter, S.C.; Waters, E.J.; Menz, R.I. Structure of haze forming proteins in white wines: Vitis vinifera Thaumatin-like proteins. PLoS ONE 2014, 9, e113757. [Google Scholar] [CrossRef]
- Gazzola, D.; Van Sluyter, S.C.; Curioni, A.; Waters, E.J.; Marangon, M. Roles of proteins, polysaccharides, and phenolics in haze formation in white wine via reconstitution experiments. J. Agric. Food Chem. 2012, 60, 10666–10673. [Google Scholar] [CrossRef] [PubMed]
- Cosme, F.; Fernandes, C.; Ribeiro, T.; Filipe-Ribeiro, L.; Nunes, F.M. White Wine Protein Instability: Mechanism, Quality Control and Technological Alternatives for Wine Stabilisation—An Overview. Beverages 2020, 6, 19. [Google Scholar] [CrossRef]
- Arenas, I.; Ribeiro, M.; Filipe-Ribeiro, L.; Vilamarim, R.; Costa, E.; Siopa, J.; Cosme, F.; Nunes, F.M. Effect of Pre-Fermentative Maceration and Fining Agents on Protein Stability, Macromolecular, and Phenolic Composition of Albariño White Wines: Comparative Efficiency of Chitosan, k-Carrageenan and Bentonite as Heat Stabilisers. Foods 2021, 10, 608. [Google Scholar] [CrossRef] [PubMed]
- Heatherbell, D.; Ngaba, P.; Fombin, J.; Watson, B.; Garcia, Z.; Flores, J.; Hsu, J. Recent developments in the application of ultrafiltration and protease enzymes to grape juice and wine processing. In Proceedings of the International Symposium on Cool Climate Viticulture and Enology, Eugene, OR, USA, 25–28 June 1984; Oregon State University: Corvallis, OR, USA, 1984; pp. 418–445. [Google Scholar]
- Waters, E.J.; Wallace, W.; Williams, P.J. Identification of heat-unstable wine proteins and their resistance to peptidases. J. Agric. Food Chem. 1992, 40, 1514–1519. [Google Scholar] [CrossRef]
- Waters, E.J.; Peng, Z.; Pocock, K.F.; Williams, P.J. Proteins in white wine, II: Their resistance to proteolysis is not due to either phenolic association or glycosylation. Aust. J. Grape Wine Res. 1995, 1, 94–99. [Google Scholar] [CrossRef]
- Theron, L.W.; Divol, B. Microbial aspartic proteases: Current and potential applications in industry. Appl. Microbiol. Biotechnol. 2014, 98, 8853–8868. [Google Scholar] [CrossRef]
- Bakalinsky, A.T.; Boulton, R. The study of an immobilized acid protease for the treatment of wine proteins. Am. J. Enol. Vitic. 1985, 36, 23–29. [Google Scholar] [CrossRef]
- Cilindre, C.; Castro, A.J.; Clément, C.; Jeandet, P.; Marchal, R. Influence of Botrytis cinerea infection on Champagne wine proteins (characterized by two-dimensional electrophoresis/immunodetection) and wine foaming properties. Food Chem. 2007, 103, 139–149. [Google Scholar] [CrossRef]
- Younes, B.; Cilindre, C.; Villaume, S.; Parmentier, M.; Jeandet, P.; Vasserot, Y. Evidence for an extracellular acid proteolytic activity secreted by living cells of Saccharomyces cerevisiae PlR1: Impact on grape proteins. J. Agric. Food Chem. 2011, 59, 6239–6246. [Google Scholar] [CrossRef]
- Marangon, M.; Van Sluyter, S.C.; Robinson, E.M.; Muhlack, R.A.; Holt, H.E.; Haynes, P.A.; Godden, P.W.; Smith, P.A.; Waters, E.J. Degradation of white wine haze proteins by Aspergillopepsin I and II during juice flash pasteurization. Food Chem. 2012, 135, 1157–1165. [Google Scholar] [CrossRef]
- Van Sluyter, S.C.; McRae, J.M.; Falconer, R.J.; Smith, P.A.; Bacic, A.; Waters, E.J.; Marangon, M. Wine protein haze: Mechanisms of formation and advances in prevention. J. Agric. Food. Chem. 2015, 63, 4020–4030. [Google Scholar] [CrossRef] [PubMed]
- Comuzzo, P.; Voce, S.; Fabris, J.; Cavallaro, A.; Zanella, G.; Karpusas, M.; Kallithraka, S. Effect of the combined application of heat treatment and proteases on protein stability and volatile composition of Greek white wines. Oeno One 2020, 54, 175–188. [Google Scholar] [CrossRef]
- Talavera-Caro, A.G.; Alva-Sánchez, D.L.; Sosa-Herrera, A.; Sánchez-Muñoz, M.A.; Hernández-De Lira, I.O.; Hernández-Beltran, J.U.; Hernández-Almanza, A.Y.; Balagurusamy, N. Chapter 11—Emerging trends and future perspectives on enzyme prospection with reference to food processing. In Value-Addition in Food Products and Processing through Enzyme Technology; Kuddus, M., Aguilar, C.N., Eds.; Academic Press: Cambridge, MA, USA, 2022; pp. 139–151. [Google Scholar] [CrossRef]
- Sharma, A.; Gupta, G.; Ahmad, T.; Mansoor, S.; Kaur, B. Enzyme Engineering: Current Trends and Future Perspectives. Food Rev. Int. 2021, 37, 121–154. [Google Scholar] [CrossRef]
- Singh, R.; Kumar, M.; Mittal, A.; Mehta, P.K. Microbial Enzymes: Industrial Progress in 21st Century. 3 Biotech 2016, 6, 174. [Google Scholar] [CrossRef] [PubMed]
- 153Yang, H.; Li, J.; Shin, H.D.; Du, G.; Liu, L.; Chen, J. Molecular engineering of industrial enzymes: Recent advances and future prospects. Appl. Microbiol. Biotechnol. 2014, 98, 23–29. [Google Scholar]
- Solano, F. Enzyme Engineering: Old and New Approaches. Enzyme Eng. 2015, 4, 1. [Google Scholar] [CrossRef]
- Cosme, F.; Vilela, A. Chitin and Chitosan in the Alcoholic and Non-Alcoholic Beverage Industry: An Overview. Appl. Sci. 2021, 11, 11427. [Google Scholar] [CrossRef]
- Kaushal, J.; Singh, G.; Arya, S.K. Chapter 36—Emerging trends and future prospective in enzyme technology. In Value-Addition in Food Products and Processing through Enzyme Technology; Kuddus, M., Aguilar, C.N., Eds.; Academic Press: Cambridge, MA, USA, 2022; pp. 491–503. [Google Scholar] [CrossRef]
- Bleve, G.; Tufariello, M.; Vetrano, C.; Mita, G.; Grieco, F. Simultaneous alcoholic and malolactic fermentations by Saccharomyces cerevisiae and Oenococcus oeni cells co-immobilized in alginate beads. Front. Microbiol. 2016, 7, 943. [Google Scholar] [CrossRef]
- Ahumada, K.; Martínez-Gil, A.; Moreno-Simunovic, Y.; Illanes, A.; Wilson, L. Aroma Release in Wine Using Co-Immobilized Enzyme Aggregates. Molecules 2016, 8, 1485. [Google Scholar] [CrossRef]
- Moirangthem, K.; Rai, D.-K.; Coda, R. Chapter 2—Enzyme technology for value addition in the beverage industry waste. In Value-Addition in Beverages through Enzyme Technology; Kuddus, M., Hossain, M., Eds.; Academic Press: Cambridge, MA, USA, 2023; pp. 27–50. ISBN 9780323856836. [Google Scholar] [CrossRef]
- Elleuche, S.; Schröder, C.; Sahm, K.; Antranikian, G. Extremozymes—Biocatalysts with unique properties from extremophilic microorganisms. Curr. Opin. Biotechnol. 2014, 29, 116–123. [Google Scholar] [CrossRef]
- Akanbi, T.O.; Agyei, D.; Saari, N. Chapter 46—Food Enzymes From Extreme Environments: Sources and Bioprocessing. In Enzymes in Food Biotechnology; Kuddus, M., Ed.; Academic Press: Cambridge, MA, USA, 2019; pp. 795–816. [Google Scholar] [CrossRef]

| Enzyme Activity | Production Microorganism | Host Organism Morphology of Colonies |
|---|---|---|
| Aminopeptidase, Arabinofuranosidase, Catalase, Cellulase, Glucanase (endo-beta), Glucanase (exo-beta), Glucanase (beta), Glucoamylase, Glucose oxidase, Lactase or galactosidase (beta), Lysophospholipase, Pectinase, Xylanase | Aspergillus niger | ![]() |
| Aminopeptidase (leucyl), Protease, Tannase | Aspergillus oryzae | ![]() |
| AMP deaminase, Protease (exopeptidase) | Aspergillus melleus and Aspergillus usamii | ![]() |
| Cellulase, Ribonuclease | Penicillium funiculosum | ![]() |
| Cellulase, Glucanase (exo-beta), Xylanase | Trichoderma reesei | ![]() |
| Dextranase | Chaetomium erraticum | ![]() |
| Glucanase (beta) | Talaromyces emersonii | Not. available |
| Lipase triacylglycerol | Candida rugosa | ![]() |
| Lipase triacylglycerol, Glucanase (endo-beta), Glucanase (exo-beta) | Rhizopus niveus | ![]() |
| Lipase triacylglycerol | Rhizopus oryzae | ![]() |
| Protease (mucorpepsin) | Rhizomucor miehei | ![]() |
| Glucanase (beta), Xylanase | Humicola insolens | Not available |
Disclaimer/Publisher’s Note: The statements, opinions and data contained in all publications are solely those of the individual author(s) and contributor(s) and not of MDPI and/or the editor(s). MDPI and/or the editor(s) disclaim responsibility for any injury to people or property resulting from any ideas, methods, instructions or products referred to in the content. |
© 2023 by the authors. Licensee MDPI, Basel, Switzerland. This article is an open access article distributed under the terms and conditions of the Creative Commons Attribution (CC BY) license (https://creativecommons.org/licenses/by/4.0/).
Share and Cite
Cosme, F.; Inês, A.; Vilela, A. Microbial and Commercial Enzymes Applied in the Beverage Production Process. Fermentation 2023, 9, 385. https://doi.org/10.3390/fermentation9040385
Cosme F, Inês A, Vilela A. Microbial and Commercial Enzymes Applied in the Beverage Production Process. Fermentation. 2023; 9(4):385. https://doi.org/10.3390/fermentation9040385
Chicago/Turabian StyleCosme, Fernanda, António Inês, and Alice Vilela. 2023. "Microbial and Commercial Enzymes Applied in the Beverage Production Process" Fermentation 9, no. 4: 385. https://doi.org/10.3390/fermentation9040385
APA StyleCosme, F., Inês, A., & Vilela, A. (2023). Microbial and Commercial Enzymes Applied in the Beverage Production Process. Fermentation, 9(4), 385. https://doi.org/10.3390/fermentation9040385